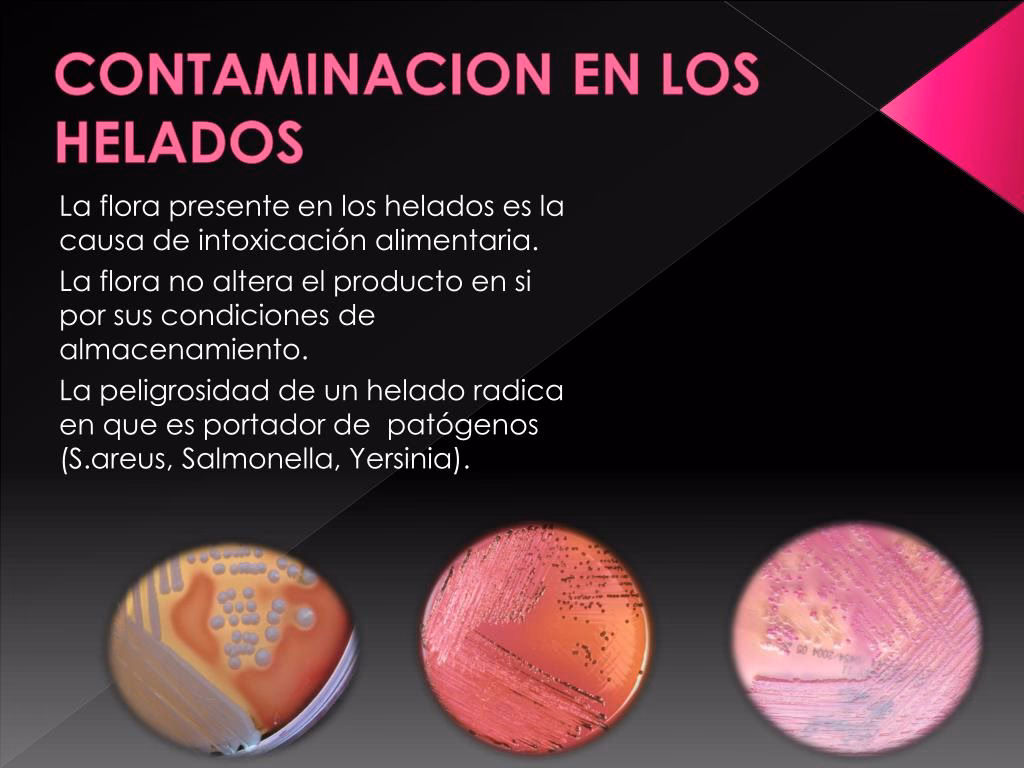

18/08/2006
El helado es, para muchos, sinónimo de alegría, verano y momentos dulces. Su textura cremosa y su frescura lo convierten en uno de los postres más queridos a nivel mundial. Sin embargo, detrás de esa apariencia inocente y deliciosa, pueden esconderse riesgos para nuestra salud y el medio ambiente si no se produce y manipula con el debido cuidado. Aunque a menudo asociamos los problemas de seguridad alimentaria con carnes o pescados, el helado, por su composición y proceso, es un producto de alto riesgo que merece toda nuestra atención. Comprender estos peligros no es para generar miedo, sino para empoderarnos como consumidores y fomentar una industria alimentaria más segura y consciente.

¿Por Qué un Postre Congelado Puede Ser Peligroso?
La principal paradoja del helado reside en el frío. Comúnmente, creemos que las bajas temperaturas eliminan cualquier amenaza, pero esto es un mito peligroso. La congelación no destruye a la mayoría de los microorganismos patógenos, como bacterias y virus; simplemente detiene su crecimiento y los pone en un estado latente, como si hibernaran. El helado, compuesto principalmente de leche, azúcar, agua y grasas, es un caldo de cultivo perfecto para estas bacterias. Si la cadena de frío se rompe en algún momento —durante el transporte, en el punto de venta o incluso en nuestro hogar— y el helado se derrite parcialmente para luego volver a congelarse, las bacterias inactivas se reactivan y pueden multiplicarse a una velocidad alarmante. Cuando lo consumimos, ingerimos una dosis potencialmente peligrosa de estos patógenos sin que el sabor, color u olor del producto se vea alterado.
Los Tres Tipos de Amenazas en tu Helado
Para garantizar la inocuidad de un alimento, los productores deben controlar tres categorías principales de peligros durante todo el proceso de fabricación. Un fallo en cualquiera de estas áreas puede convertir un postre delicioso en un riesgo para la salud.
1. Peligros Biológicos: Los Invasores Invisibles
Son la amenaza más común y peligrosa. Se refieren a la contaminación por microorganismos patógenos. En el helado, los más preocupantes son:
- Salmonella: A menudo asociada a los huevos crudos o a la leche no pasteurizada, puede causar fiebre, diarrea y calambres abdominales.
- Listeria monocytogenes: Es especialmente peligrosa porque puede crecer a temperaturas de refrigeración. Puede causar listeriosis, una infección grave, especialmente para embarazadas, recién nacidos, ancianos y personas con sistemas inmunitarios debilitados.
- Escherichia coli (E. coli): Ciertas cepas pueden causar graves intoxicaciones alimentarias. La contaminación suele provenir de una higiene deficiente del personal o del uso de agua contaminada.
Estos microorganismos pueden llegar al helado a través de materias primas contaminadas, equipos mal higienizados o, más comúnmente, por una manipulación inadecuada por parte del personal.
2. Peligros Químicos: Sustancias Indeseadas
Esta categoría incluye la presencia de sustancias químicas tóxicas. Aunque menos frecuentes, los riesgos existen:
- Residuos de agentes de limpieza: Si los equipos de producción no se enjuagan correctamente después de la desinfección, los productos químicos pueden terminar en la mezcla del helado.
- Alérgenos no declarados: La contaminación cruzada es un riesgo químico grave. Si en una misma línea de producción se elabora un helado de fresa y luego uno de pistacho sin una limpieza exhaustiva, trazas de frutos secos pueden contaminar el helado de fresa, suponiendo un peligro mortal para una persona alérgica.
- Pesticidas: Frutas u otros ingredientes de origen vegetal pueden contener residuos de pesticidas si no se han seguido las buenas prácticas agrícolas.
3. Peligros Físicos: Objetos Extraños
Se refiere a la presencia de cualquier objeto ajeno al alimento. Estos pueden causar lesiones como cortes o asfixia. Algunos ejemplos son:
- Fragmentos de vidrio, metal o plástico desprendidos de la maquinaria.
- Cabello, trozos de uñas o joyas del personal manipulador.
- Astillas de madera de paletas o insectos.
El Manipulador: Héroe o Villano en la Seguridad del Helado
La figura del manipulador de alimentos es absolutamente crucial. Una sola persona con malos hábitos de higiene puede contaminar lotes enteros de producción. Las normativas de seguridad alimentaria, como el sistema de Análisis de Peligros y Puntos Críticos de Control (APPCC), ponen un énfasis enorme en la formación y el comportamiento del personal. Unas manos mal lavadas, toser o hablar sobre la mezcla, o usar utensilios sucios son puertas de entrada para millones de bacterias.
Tabla Comparativa: Prácticas de Riesgo vs. Buenas Prácticas
| Práctica de Riesgo | Buena Práctica de Manipulación (BPM) | Peligro que se Evita |
|---|---|---|
| No lavarse las manos con frecuencia. | Lavado de manos riguroso con agua y jabón antes de empezar, después de ir al baño o tocar cualquier superficie sucia. | Contaminación biológica (E. coli, Salmonella). |
| Hablar, comer o toser sobre la mezcla del helado. | Uso de mascarilla y prohibición de comer o beber en el área de producción. | Contaminación por microgotas de saliva (bacterias y virus). |
| Colocar recipientes o materias primas en el suelo. | Utilizar siempre estanterías y superficies limpias y elevadas del suelo. | Contaminación física (suciedad) y biológica. |
| Usar la misma cuchara para servir diferentes sabores. | Utilizar una cuchara limpia para cada sabor o enjuagarla en agua corriente entre servicios. | Contaminación cruzada de alérgenos y sabores. |
¿Cómo se Garantiza un Helado Seguro? El Sistema APPCC
Para combatir estos riesgos, la industria alimentaria moderna utiliza sistemas de gestión preventiva como el APPCC (Análisis de Peligros y Puntos Críticos de Control). En lugar de simplemente analizar el producto final, este sistema se enfoca en prevenir la contaminación en cada etapa del proceso. Identifica los "puntos críticos de control", que son las fases donde el riesgo es mayor y donde una medida de control puede eliminarlo o reducirlo a un nivel seguro. En la fabricación de helado, algunos de estos puntos son:
- Recepción de materias primas: Verificar que la leche, los huevos y las frutas provengan de proveedores fiables y lleguen en condiciones óptimas.
- Pasteurización: Calentar la mezcla a una temperatura específica durante un tiempo determinado para eliminar la mayoría de las bacterias patógenas. Es quizás el paso más crítico.
- Enfriamiento y maduración: Bajar la temperatura de la mezcla rápidamente para evitar que las bacterias que sobrevivieron a la pasteurización se multipliquen.
- Congelación y almacenamiento: Mantener el producto a temperaturas de -18°C o inferiores de forma constante para preservar su seguridad y calidad.
Un programa de limpieza y desinfección riguroso, junto con la capacitación continua del personal, son los pilares que sostienen este sistema preventivo.
Preguntas Frecuentes (FAQ)
¿El frío intenso del congelador mata las bacterias del helado?
No. La congelación solo las inactiva. En cuanto la temperatura sube, pueden volver a activarse y multiplicarse. Por eso es vital no romper la cadena de frío.
¿Es seguro comer helado que se ha derretido y vuelto a congelar?
No es recomendable. Si el helado ha perdido su forma y presenta cristales de hielo grandes y crujientes, es una señal de que la cadena de frío se ha roto. El riesgo de proliferación bacteriana es alto, por lo que es más seguro desecharlo.
¿Los helados caseros son más seguros que los industriales?
No necesariamente. La seguridad depende enteramente de la higiene durante su preparación y de la calidad de los ingredientes. Usar huevos no pasteurizados o no limpiar bien los utensilios puede hacer que un helado casero sea mucho más peligroso que uno industrial producido bajo estrictos controles.
¿Qué es la "contaminación cruzada" en una heladería?
Ocurre cuando los microorganismos o alérgenos se transfieren de un alimento a otro. El ejemplo más claro es usar la misma cuchara (portabolas) para un helado de avellana y luego para uno de limón. Las trazas de avellana pueden provocar una reacción alérgica grave en una persona sensible.
En conclusión, disfrutar de un helado no tiene por qué ser un riesgo. Como consumidores, tenemos el poder de elegir establecimientos que visiblemente se preocupan por la higiene y la calidad. Apoyar a productores que son transparentes con sus procesos y que invierten en la seguridad de sus productos no solo protege nuestra salud, sino que también fomenta un sistema alimentario más responsable y sostenible. La próxima vez que pidas tu sabor favorito, recuerda que detrás de ese placer momentáneo hay una compleja cadena de cuidado y ciencia para garantizar que sea tan seguro como delicioso.
Si quieres conocer otros artículos parecidos a Helado: Los Riesgos Ocultos en tu Postre Favorito puedes visitar la categoría Ecología.